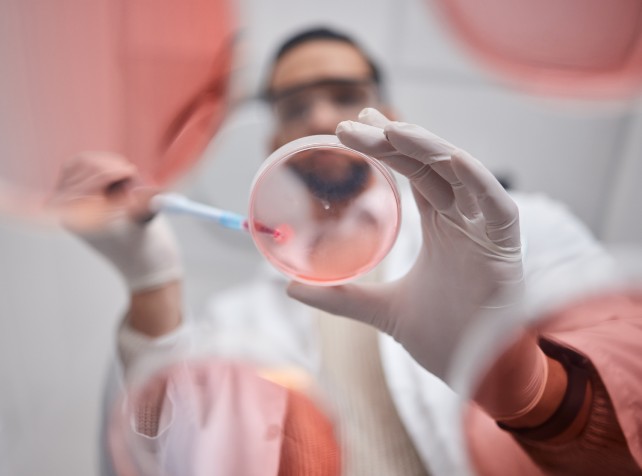

Cancer patients and women with hormonal disorders are among those who may benefit from a breakthrough fertility treatment that eliminates a gruelling two weeks worth of injections.
Melbourne GP Jilly Gallagher, who has undergone three rounds of egg freezing, says the standard IVF process comes at an enormous emotional and physical cost.
Subscribe for FREE to the HealthTimes magazine
"Each cycle, you're having to do two weeks of injections into your stomach with hormones that make you feel very bloated and in pain," she told AAP.
"You can feel emotional or irritable and the bloating continues even after they've collected your eggs until your next period, so it's about a month of discomfort."
Injections leave bruises and the recovery is disruptive, sometimes forcing her away from work.
"As a GP I'm self-employed, so there's no sick pay. Cancelling at the last minute affects my patients too," Dr Gallagher said.
A Victorian-first pilot study of a less-intensive alternative that skips the traditional injecting process is being launched by Melbourne IVF.
Any efforts to ease the burdens are a welcome one, Dr Gallagher said.
The six-month pilot study of CAPA-IVM, an internationally backed process that has also been used in NSW, shortens the two-week hormonal injections to one or two days.
In traditional IVF, women use hormone injections for around two weeks to help the ovaries mature multiple eggs at once, allowing several to be collected in a single IVF cycle.
Instead of maturing eggs inside the body, immature "tiny" eggs will be retrieved and matured in a laboratory using an advanced culture system - a process known as in vitro maturation.
It requires little or no ovarian stimulation which means the egg collection procedure can potentially be organised within one to four days of assessment.
"Normally it takes 10 to 13 days of hormone injections to grow a pool of eggs," Associate Professor Kate Stern, clinical director and fertility expert at Melbourne IVF said.
"That involves sometimes gruelling hormone treatment and frequent visits to the hospital.
"The idea with in vitro maturation is that you have either zero, or only one or two days of injections, so you don't develop the bloating, increased risk of clots, and doesn't take the time, energy, stress and trauma."
While not yet as effective as standard IVF, Assoc Prof Stern said the technique could benefit several groups including patients who find hormone treatment traumatic, women with polycystic ovary syndrome and cancer patients who may not have time for conventional cycles.
"As with a lot of our research for cancer fertility preservation, this has had implications and benefits for our wider fertility population," she said.
"Mainly it's about offering different options that suit different patients, making it safer and giving our cancer patients more options."
The first baby in Australia conceived through CAPA-IVM was in 2023, after the method was used at The Royal Hospital for Women in Sydney.
If the Victorian pilot confirms the benefits of CAPA-IVM, Assoc Prof Stern said the aim will be to integrate it into broader clinical care at Melbourne IVF.
Success will be measured through the ability to develop mature eggs from the smaller eggs, the ability to fertilise the eggs and patient satisfaction.
Women aged between 21 to 37 are being invited to register their interest.